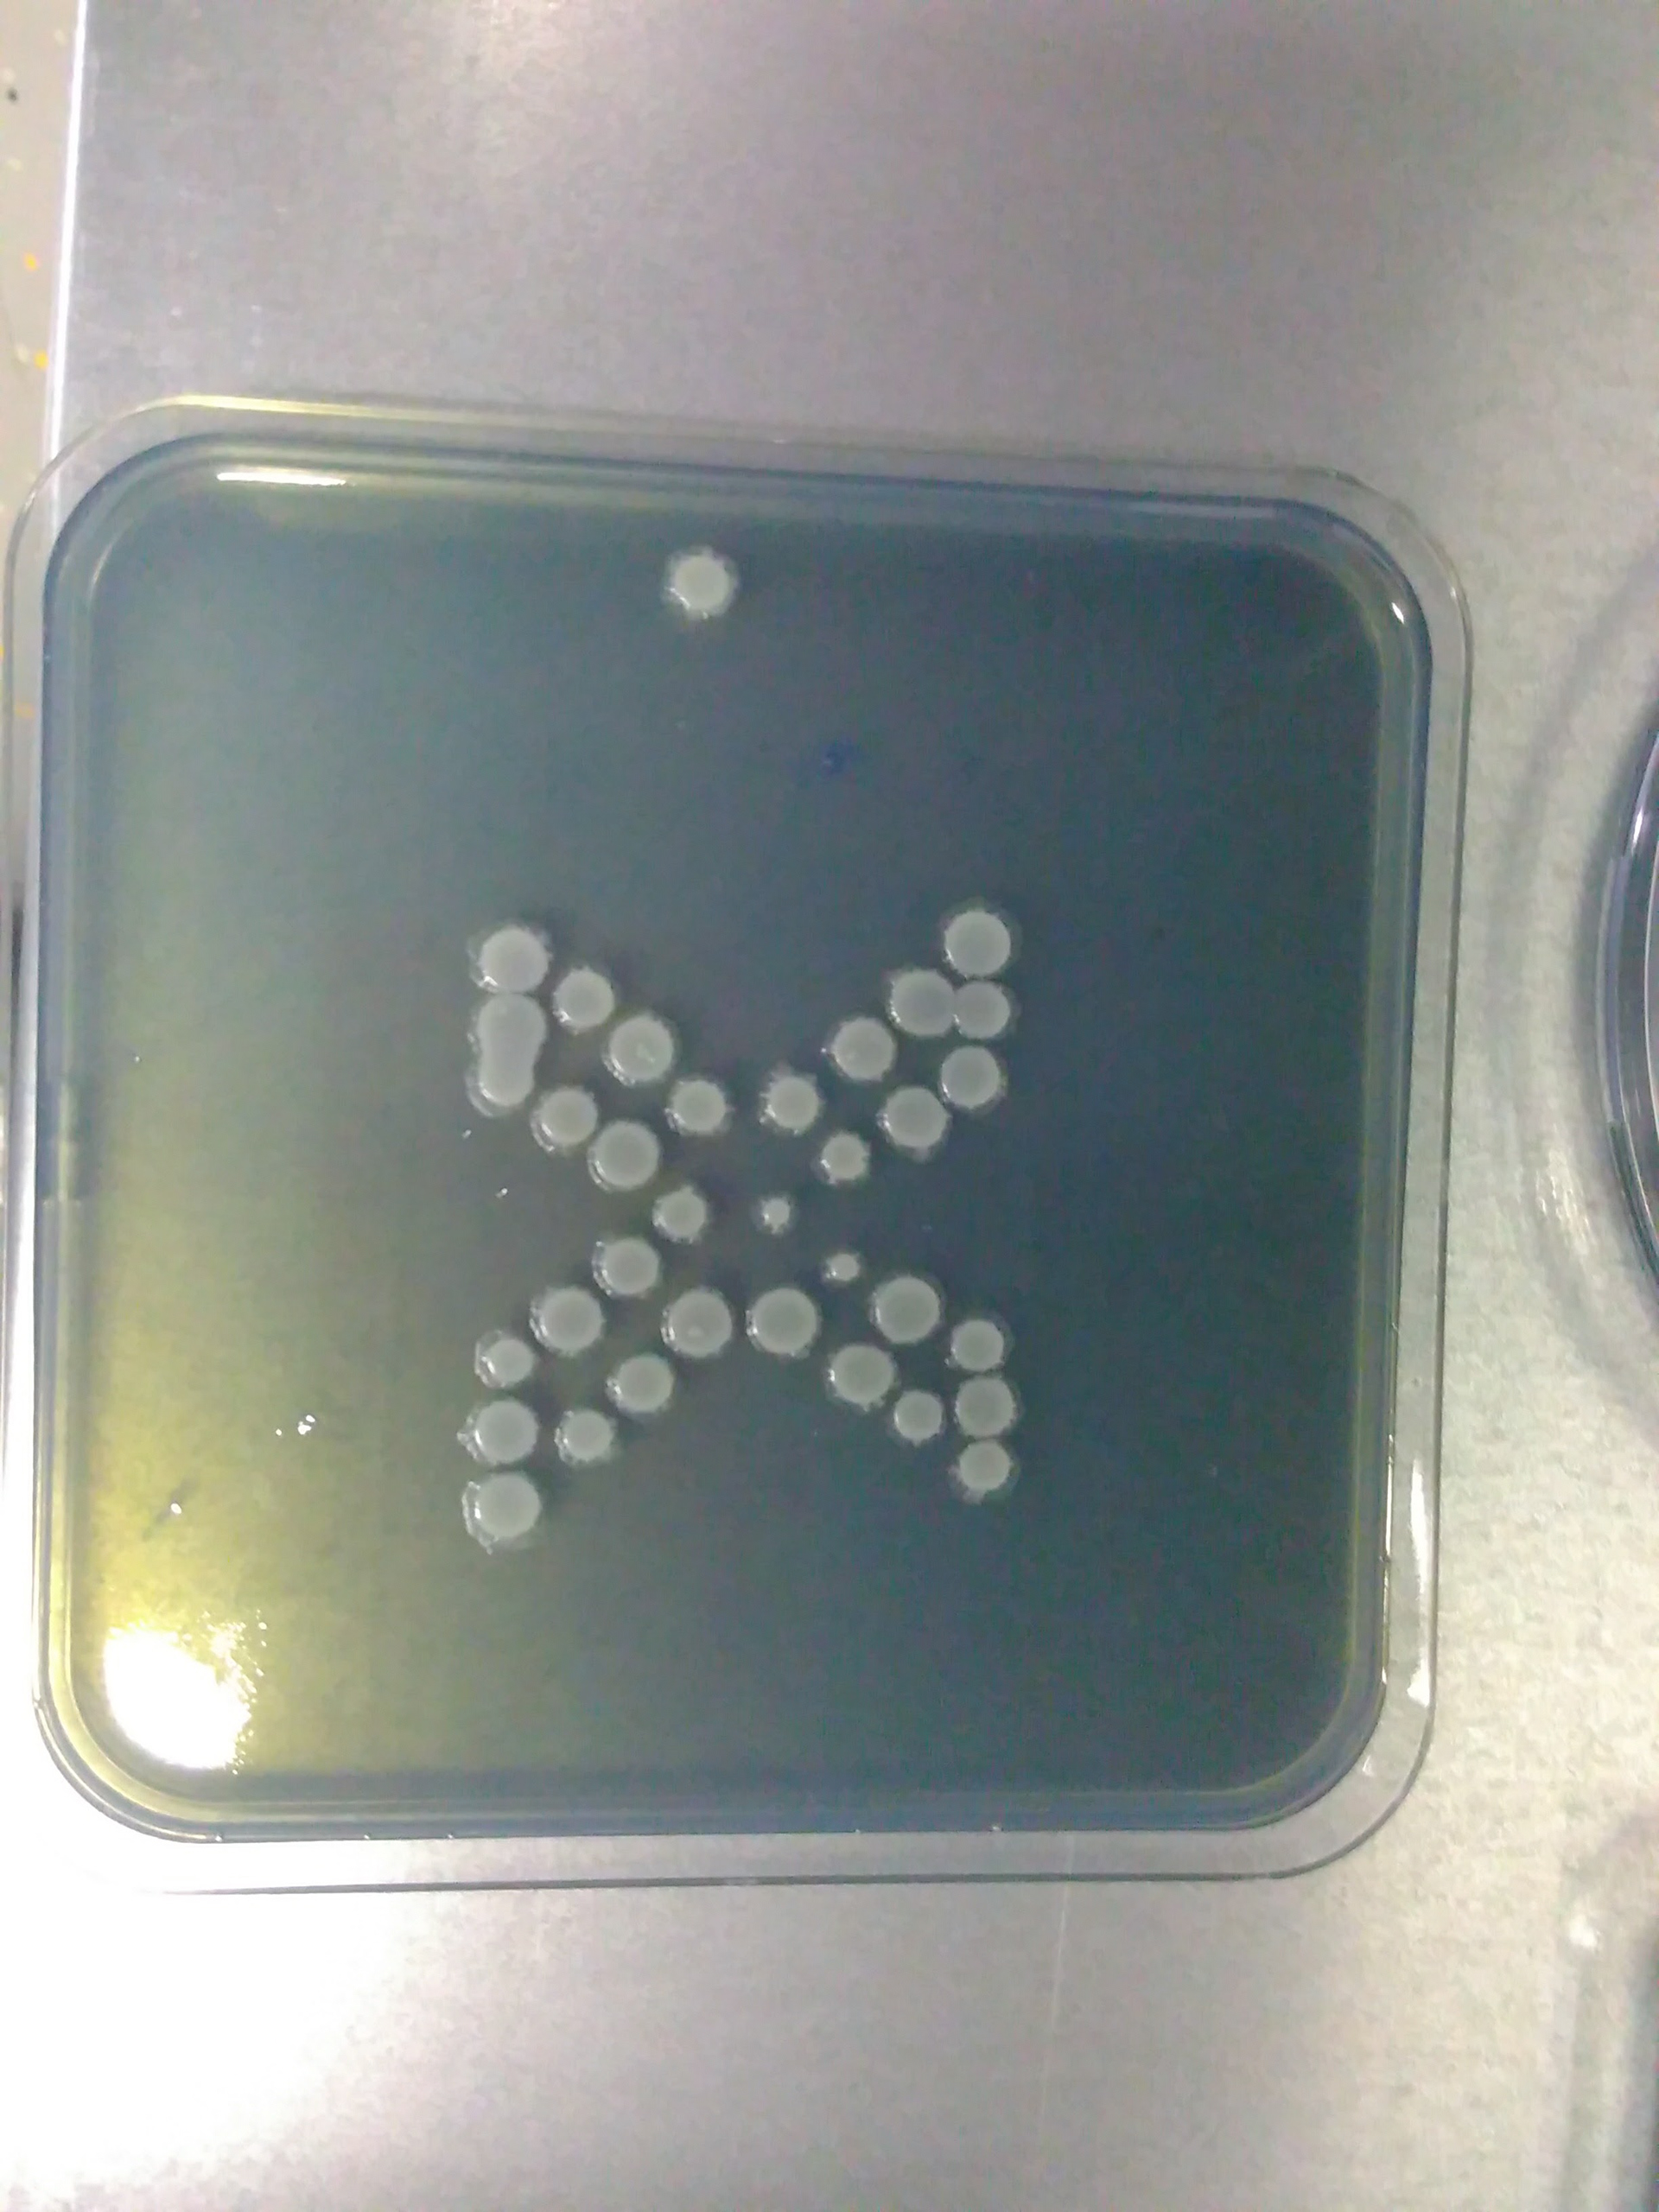
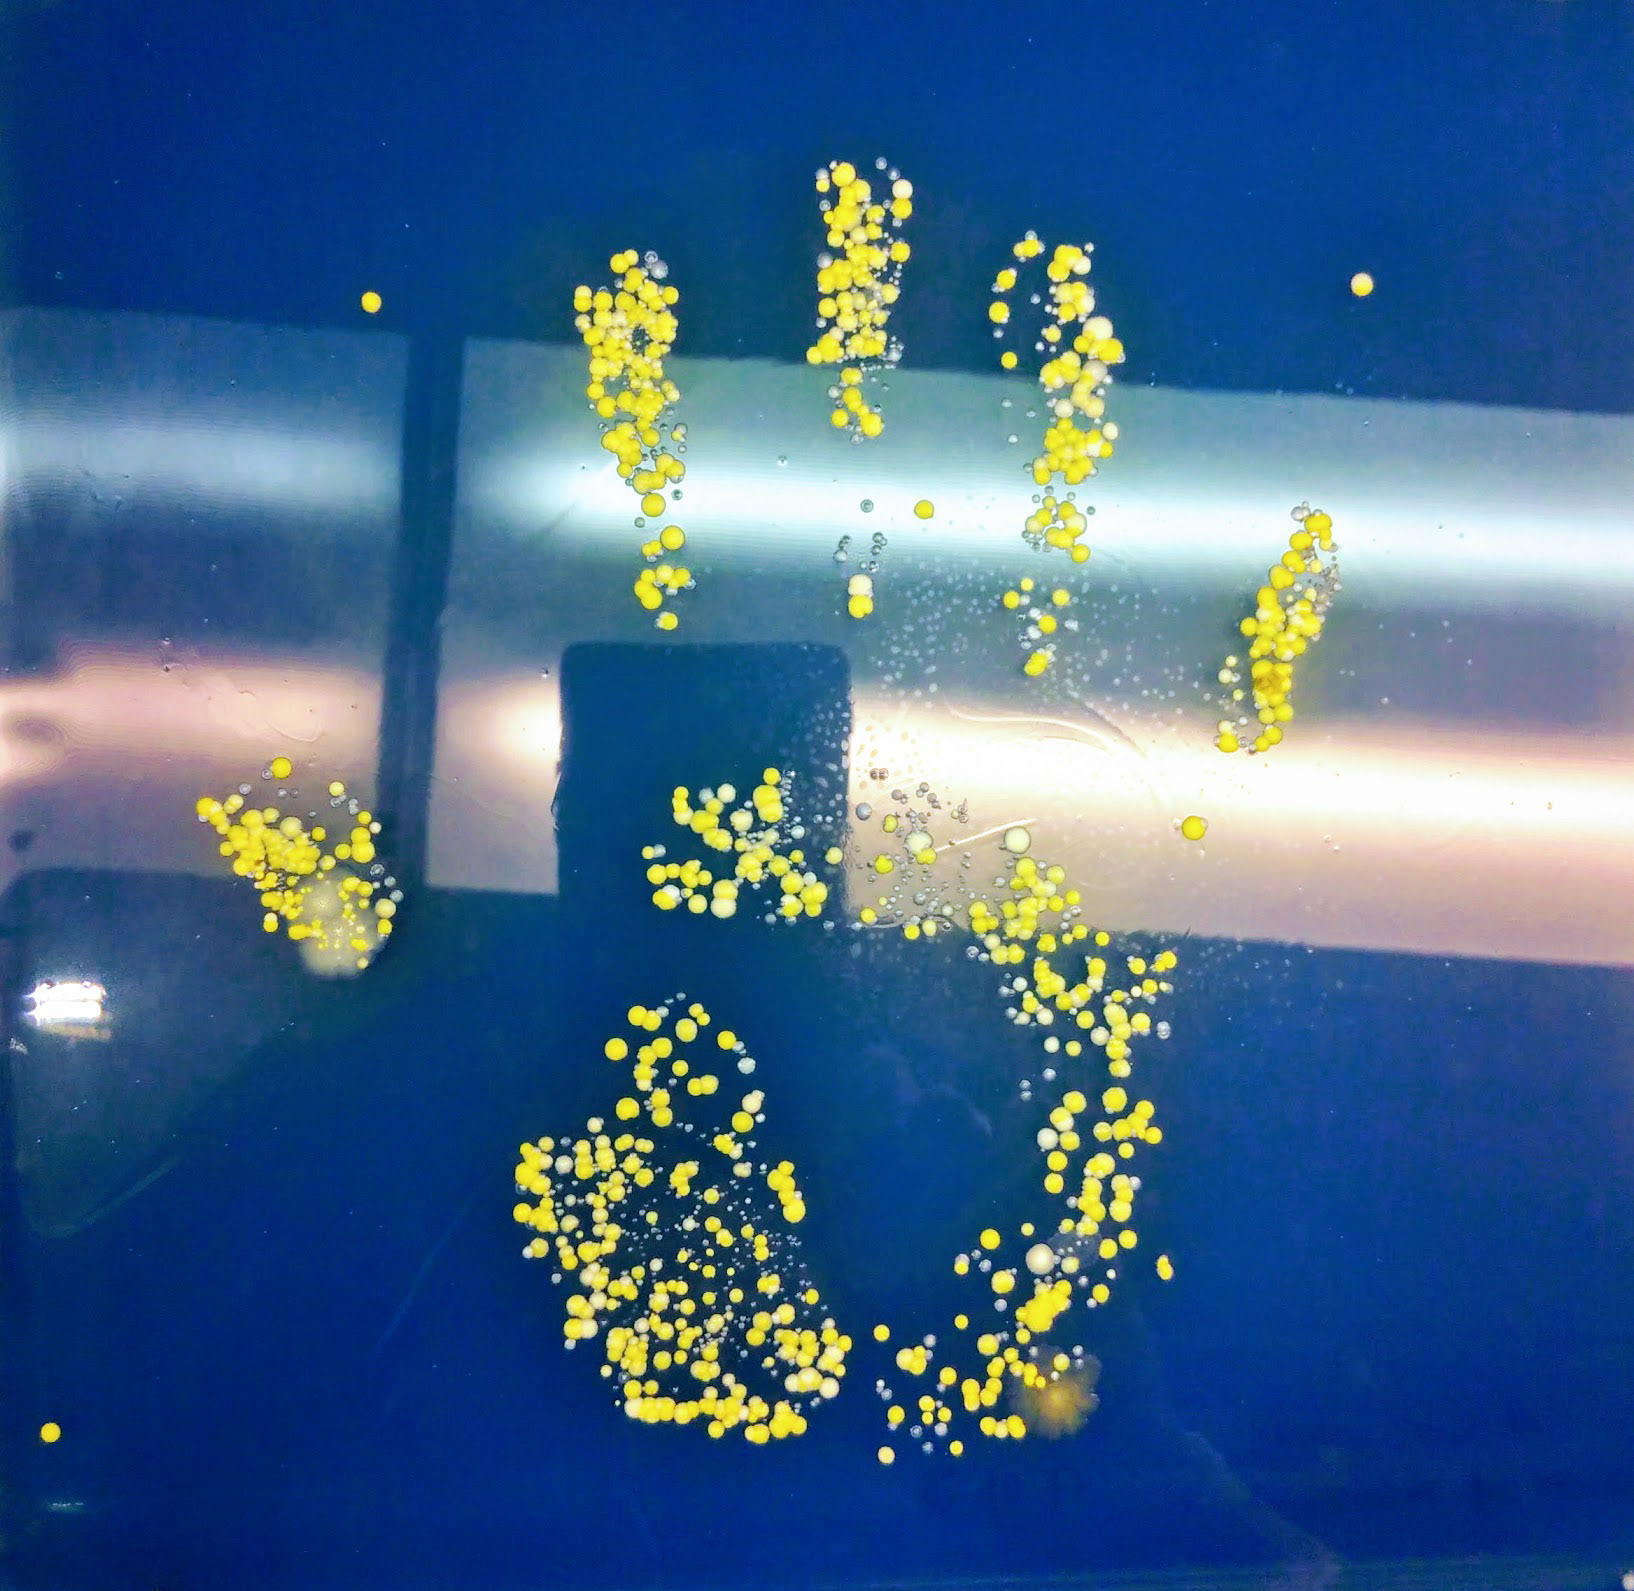

Bioprinting, Hello Future
For this workshop we will work with bio - pigments extracted from plants, bacteria and algae, also with bioprinting (printing with living bacteria). Biological pigments, bio-pigments or bio-chromes, are colored particles or substances produced by living organisms that have a color resulting from selective color absorption. Biological pigments include bacteria, plant pigments and flower pigments. Many biological structures, such as skin, eyes, feathers, fur and hair contain pigments such as melanin in specialized cells called chromatophores. Pigment color differs is the same for all viewing angles, whereas structural color butterfly wings is the result of selective reflection or iridescence, usually because of multi-layer structures.
Bioprinter Documentation:








